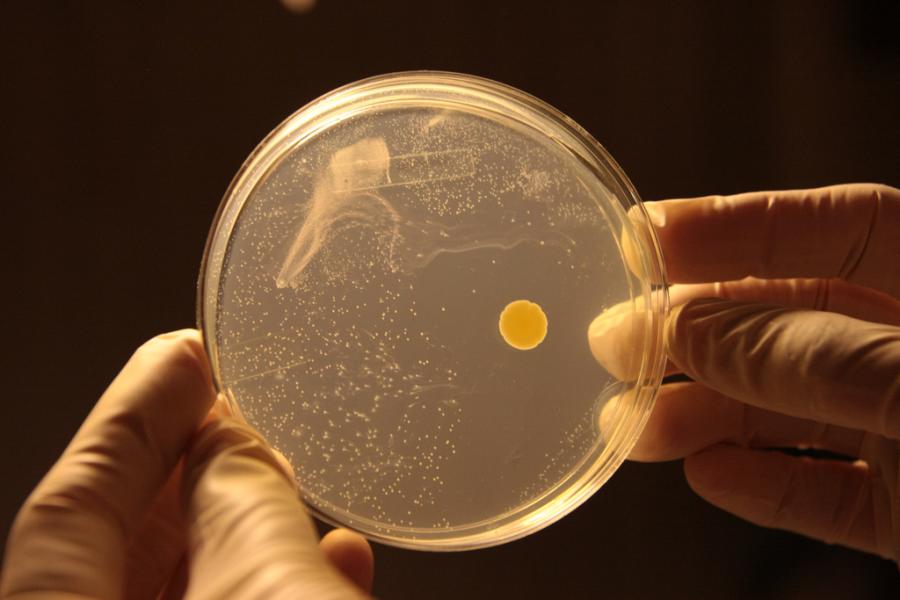

Мир
Йемен пообещал атаковать все израильские суда в случае операции в Рафахе
USD 92,0538 EUR 98,6447
Главная » НОВОСТИ » Общество » Бактерии на МКС мутировали в условиях космоса в неизвестные формы, устойчивые к земным лекарствам
23.04.2024 09:55
При сотрудничестве с Лабораторией реактивного движения НАСА группа индийских исследователей провела анализ штаммов бактерий с МКС и сравнила их с такими же видами на Земле. Об этом сообщает Phys.org и журнал Microbiome.
Они выяснили, что космические бактерии значительно отличаются от земных как функционально, так и генетически. Также, они оказались более устойчивыми к лечению, что может иметь серьезные последствия, учитывая планы НАСА и других агентств начать долгосрочные миссии с участием людей на Луне и в ее окрестностях, а также создать сеть частных космических станций вблизи Земли.
Органическая жизнь эволюционирует и адаптируется к окружающей среде, в которой она обитает. Бактерии на МКС размножаются настолько быстро, что организмы на станции значительно отличаются от их земных аналогов. Среда на МКС представляет собой герметичный пузырь с рециркулируемым воздухом, высоким уровнем радиации и микрогравитацией, что создает условия, отличные от земных. В связи с этим невозможно предсказать, как будут эволюционировать бактерии на такой станции.
Исследователи сфокусировались на одной бактерии, особо успешно приспособившейся к жизни на МКС - Enterobacter bugandensis. Они выделили 13 штаммов бактерий из образцов МКС. E.bugandensis, обычно обитающая в пищеварительном тракте человека, в некоторых случаях может вызывать клинические инфекции, особенно у детей.
Анализ образцов со всех частей МКС показал, что E.bugandensis преобладает на станции, однако не в таком виде как была на Земле. Команда исследователей отметила, что бактерии, выделенные из образцов МКС, демонстрируют более высокую толерантность к антибактериальным средствам, а также имеют более высокую способность поддерживать присутствие других микроорганизмов. Исследование показало, что колонии E.bugandensis особенно хорошо защищают грамположительные бактерии, такие как Staphylococcus saprophyticus, обитающие на космической станции.
Все права защищены. При перепечатке ссылка на сайт ИА "Грозный-информ" обязательна.
Нашли ошибку в тексте? Выделите ее мышкой и нажмите: Ctrl+Enter
Поделиться: